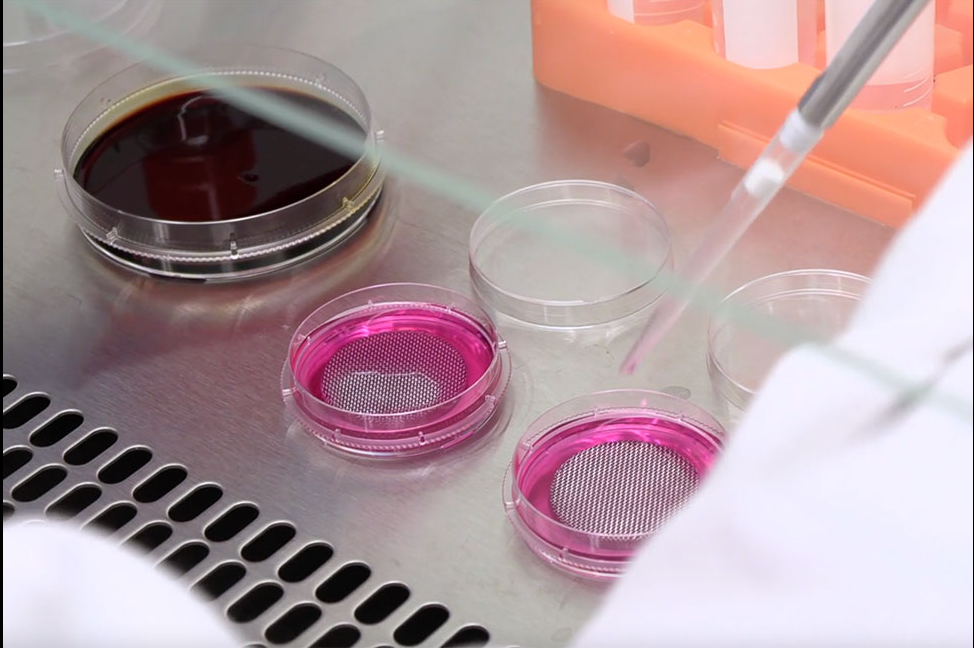
Os pesquisadores desenvolveram a pomada ao longo de 10 anos. Foto: Reprodução/Freepik.

Pesquisadores criam superpomada que restaura lesões na pele causadas pelo sol

Se você tem problemas causados pelo sol, essa superpomada pode ser a solução: ela cura as lesões que ocorrem ao longo do dia quando a pele é exposta à luz solar ou toxinas ambientais. Revolucionário!
O medicamento é um creme de melanina sintética, que imita a melanina natural da pele humana e pode ser aplicada nas feridas. Os resultados mostraram que a pomada acelera a cicatrização dos machucados na pele e elimina os radicais livres, que podem resultar em envelhecimento e câncer de pele.
“A melanina sintética estabiliza e coloca a pele no caminho de cura, que vemos tanto nas camadas superiores quanto em todo o corpo”, disse Nathan Gianneschi, co-autor do estudo e professor de Engenharia BIomédica e Farmacologia da Universidade de Northwestern, Estados Unidos.
Melanina humana
A melanina, em humanos e animais, é responsável por fornecer pigmentação à pele, olhos e cabelos. Também protege as células dos danos causados pelo sol, aumentando a pigmentação quando a luz solar é maior.
O mesmo pigmento ajuda a eliminar os radicais livres, em resposta à poluição ambiental que acontece por fontes industriais e gases de automóveis.
Assim, os pesquisadores tentaram reproduzir a substância de forma artificial, e os resultados foram incríveis!
Superpomada contra lesões
Os cientistas trabalhavam no estudo há quase 10 anos e foi publicado na revista científica Nature npj Regenerative Medicine.
Segundo Kurt Lu, um dos autores do estudo e professor de Medicine, normalmente as pessoas não se atentam aos impactos na pele.
“Se você andar descalço todos os dias ao sol, sofrerá um bombardeio constante e de baixo grau de luz ultravioleta. Isso piora durante os horários de pico do meio-dia e no verão. Sabemos que a pele exposta ao sol envelhece versus a pele protegida por roupas”, disse.
Assim, a pomada foi criada para curar as feridas, que aparecem com o tempo, e proteger a pele de toda essa exposição.
“Ele protegeu a pele e as células da pele contra os danos. Você pode colocá-lo antes de sair ao sol e depois de tomar sol. Em ambos os casos, demonstramos redução de danos e inflamação na pele. Você protege e repara a pele ao mesmo tempo, é um reparo contínuo”, explicou Kurt.
Leia mais notícia boa
- Butantan desenvolve pomada cicatrizante que cura feridas sem deixar queloide
- Pesquisadoras brasileiras criam pomada natural que cura feridas de diabéticos
- Instituto Butantan cria pomada contra picada letal de aranha
Reação na pele humana
Para comprovar ainda mais a eficácia do medicamento, os pesquisadores fizeram um teste com uma amostra de tecido de pele humana.
Usando um produto químico, Kurt e Nathan criaram uma reação na pele de queimadura.
“Estava muito inflamado, como uma reação à hera venenosa”, explicou Kurt.
Depois de um tempo, eles aplicaram a superpomada de melanina artificial no tecido. A dupla queria ver qual seria a resposta imunológica.
Nos primeiros dias, o creme facilitou a resposta do organismo, ajudando a recuperar enzimas que eliminam radicais livres.
Em seguida, o medicamento ajudou a interromper a produção de proteínas inflamatórias.
“Isso iniciou uma cascata de respostas nas quais observaram taxas de cura aumentadas, incluindo a preservação de camadas saudáveis da pele por baixo”, disseram em comunicado.

Maca hospitalar por controle de voz criada por brasileiros ganha prêmio em Portugal
Maca hospitalar por controle de voz criada por brasileiros ganha prêmio em Portugal Médicos aplaudem de pé novo remédio contra câncer de pâncreas: dobra sobrevida e reduz mortes em 60%
Médicos aplaudem de pé novo remédio contra câncer de pâncreas: dobra sobrevida e reduz mortes em 60% Fiocruz vai produzir remédio de alto custo contra esclerose múltipla para SUS
Fiocruz vai produzir remédio de alto custo contra esclerose múltipla para SUS SUS terá cirurgia robótica e 23 remédios de alto custo para vários tipos de câncer, anuncia o governo
SUS terá cirurgia robótica e 23 remédios de alto custo para vários tipos de câncer, anuncia o governo Cuscuz melhora intestino e baixa colesterol; confirmam médicos
Cuscuz melhora intestino e baixa colesterol; confirmam médicos Remédio caro que retarda Alzheimer chega ao Brasil em junho
Remédio caro que retarda Alzheimer chega ao Brasil em junho Cirurgia de dentista brasileiro ajuda bebê a voltar a mamar e emociona mãe em Angola; vídeo
Cirurgia de dentista brasileiro ajuda bebê a voltar a mamar e emociona mãe em Angola; vídeo Menino adota 2 dos 4 filhotes que achou abandonados na rua: “pra que fazer isso?”; vídeo
Menino adota 2 dos 4 filhotes que achou abandonados na rua: “pra que fazer isso?”; vídeo Menino chora com festa surpresa de aniversário dos amiguinhos na escola: “se sentir amado”; vídeo
Menino chora com festa surpresa de aniversário dos amiguinhos na escola: “se sentir amado”; vídeo João Fonseca chega às quartas de Roland Garros e fatura milhões; Guga chorou
João Fonseca chega às quartas de Roland Garros e fatura milhões; Guga chorou Shakira mostra ensaio com crianças de Uganda para a final da Copa do Mundo; vídeo
Shakira mostra ensaio com crianças de Uganda para a final da Copa do Mundo; vídeo